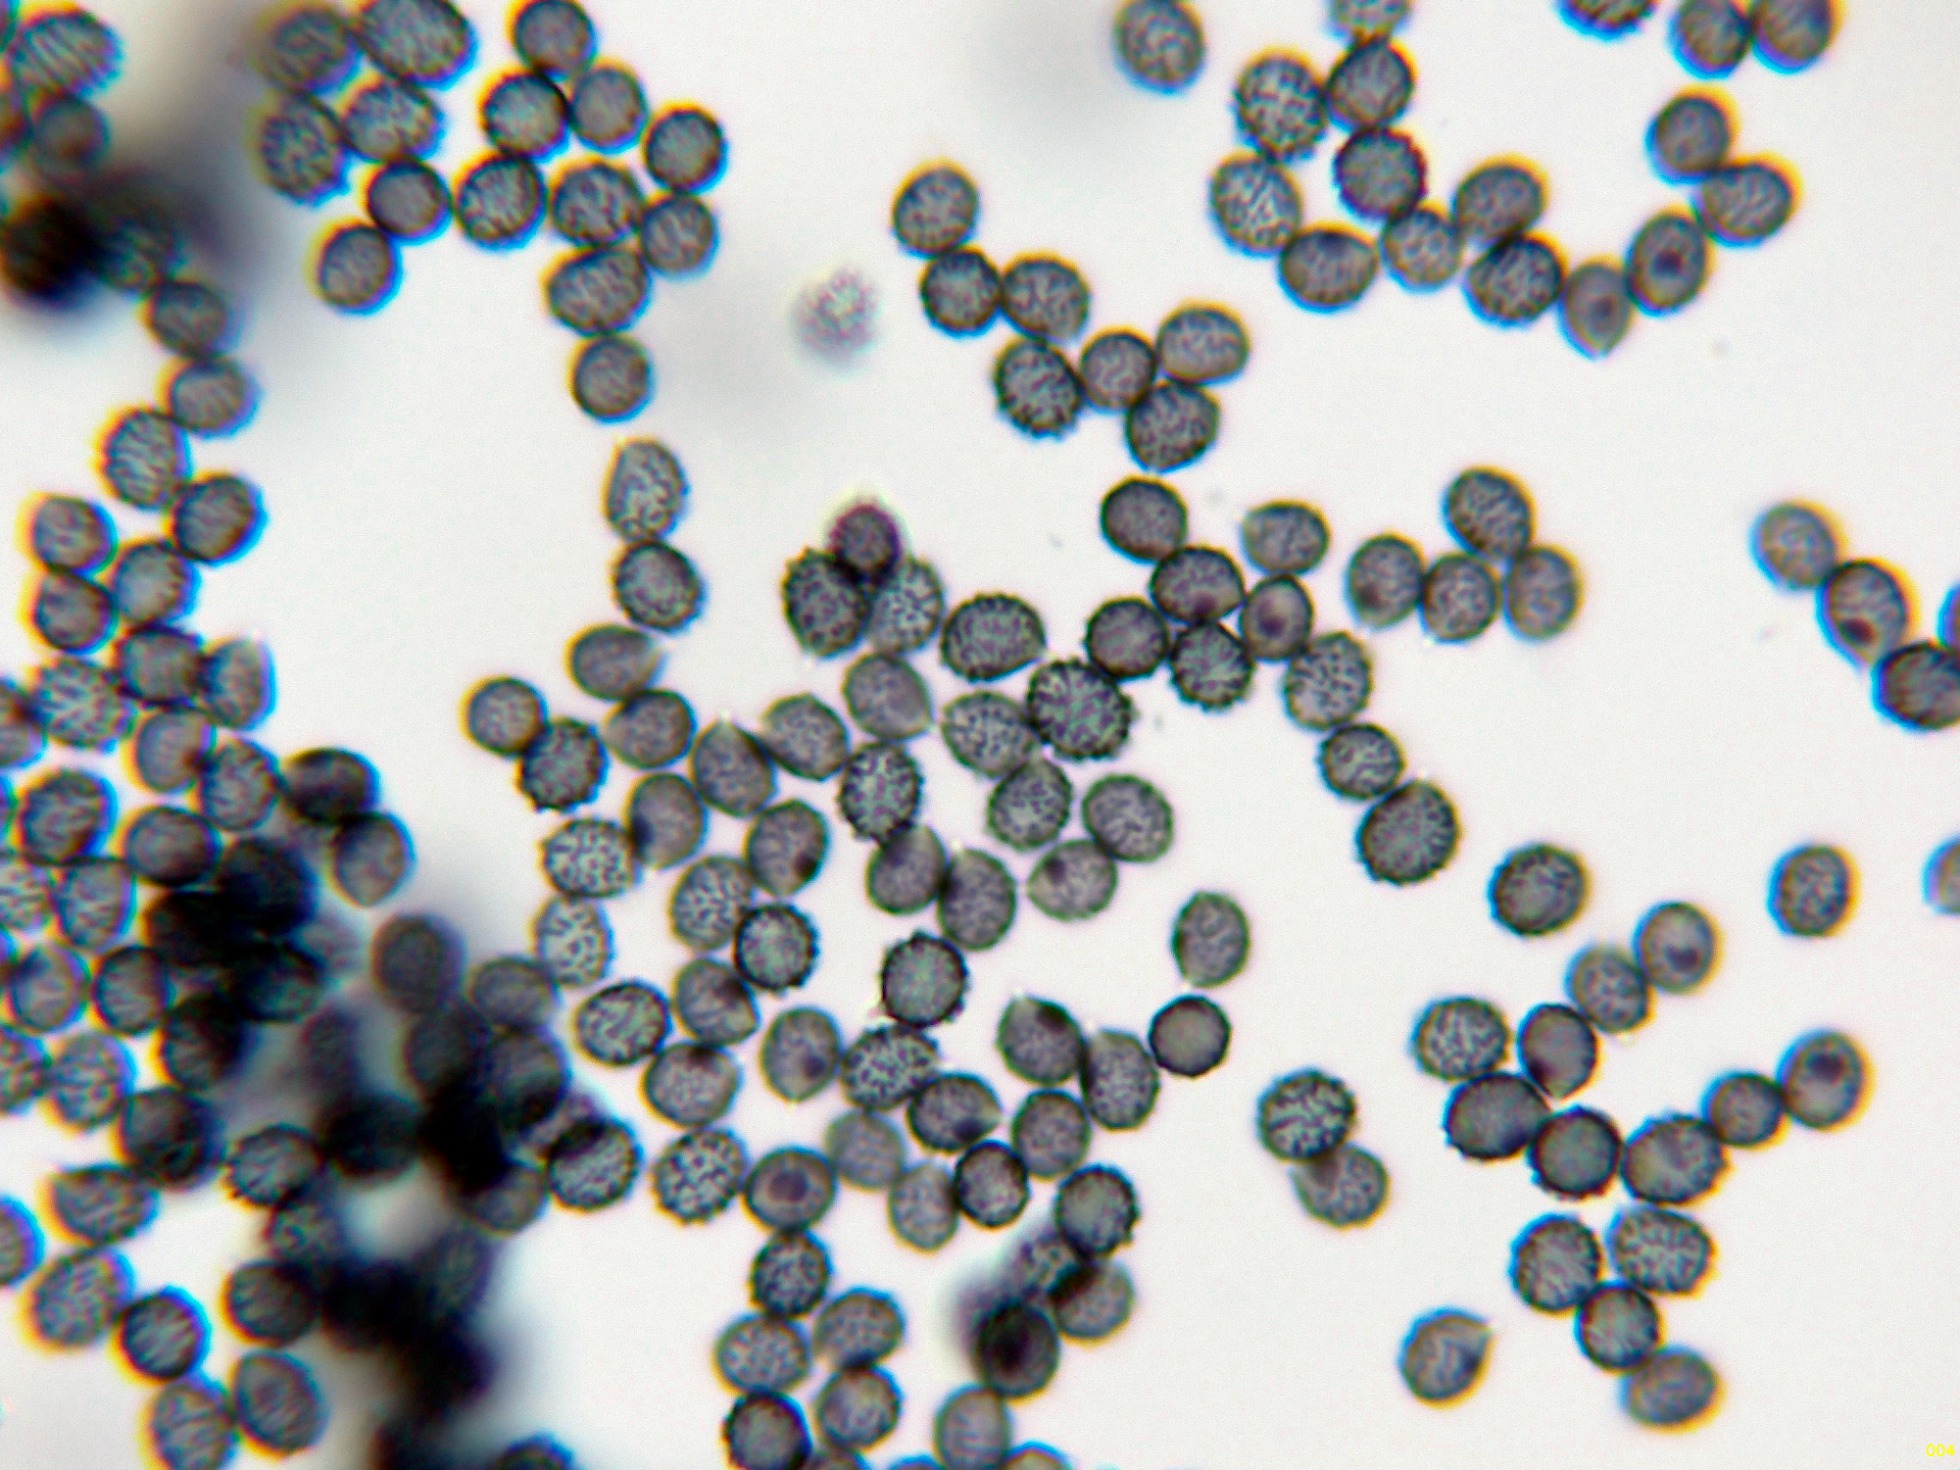

- Foro
- Foros sobre Micología de fungipedia
- Microscopía
- En agradecimiento a los Fungimasters: Russula pectinatoides Peck
 En agradecimiento a los Fungimasters: Russula pectinatoides Peck
En agradecimiento a los Fungimasters: Russula pectinatoides Peck
- Josep Torres
-
 Autor del tema
Autor del tema
- Fuera de línea
- Moderador
-

Menos
Más
- Mensajes: 8746
- Gracias recibidas: 8379
1 año 10 meses antes - 1 año 10 meses antes #109980
por Josep Torres
Hola a tod@s.
Una Russula de las dos que me mandaron los Fungimasters, ante las numerosas dudas que me surgieron a la hora de ponerle apellido, no tuve más remedio que recurrir al análisis molecular, adjunto el resultado del Blast.
Los datos moleculares no parecen dejar lugar a dudas, con una coincidencia del 100%, tanto en lo que se refiere a cobertura como en identidad, apuntado claramente a la:
Russula pectinatoides Peck
Un poco rotas me llegaron las muestras
Esporada en masa de color amarillo IVa-IVb en la escala de Romagnesi.
Reacción débil de las láminas con la Sulfovainillina a tonos entre rosados a violáceos.
Reacción ante el Sulfato ferroso (izquierda) y ante el Guayacol (derecha).
Dermatocistidios dispersos en la suprapellis, con unas medidas de (52.2) 52.23 - 66.7 × (4.8) 4.82 - 6.5 µm., que no se tiñen con la Sulfovainillina.
Los dermatocistidios en agua.
Dermatocistidios en Sulfovainillina.
Cistidios presentes tanto en la arista como en la cara laminar, con unas medidas de (41.9) 48.4 - 63 (63.2) × (7) 7.8 - 11.4 (12.2) µm.
Queilocistidios en Rojo Congo diluido.
Los pleurocistidios.
Basidios con unas medidas de (27.5) 28.5 - 39.6 (41.5) × (7.3) 7.6 - 9 (9.5) µm.
Las esporas obtenidas por esporulación natural y en Reactivo de Melzer.
Estas esporas con unas medidas de:
(5.7) 6.4 - 7.3 (7.8) × (4.9) 5.2 - 5.9 (6.3) µm
Q = (1.1) 1.2 - 1.3 ; N = 30
Me = 6.8 × 5.6 µm ; Qe = 1.2
Observaciones: Aunque ya desde un primer momento tan solo por su borde del sombrero fuertemente acanalado, intuí claramente que se trataba de una Russula dentro de la Sección Pectinatinae, no consideré a la Russula pectinatoides porque se indica un color de esporada de color crema oscuro IIc-IId, muy lejos de la esporada amarilla de mi propuesta (IVa-IVb), tampoco me termina de encajar el comportamiento frente al Sulfato Ferroso, que debería virar a gris rosado y en este caso viró a crema pálido, tampoco el sabor de las láminas que debería de ser acre, y a mí me parecieron dulces.
Parece claro que en el tema de las Russulas, de cuantos más datos dispones, más dudas surgen acerca de su identidad, por lo que en todos los casos termino secuenciando, ya llevo cierto tiempo sin fijarme en ellas, tan solo por lo complicadas que son.
Para terminar añado el árbol filogenético, en esta ocasión he escogido las 20 Russulas más cercanas a mi propuesta, utilizando como Clado externo la Russula amerorecondita.
Mi propuesta se encuentra dentro del clado de la Russula pectinatoides y la Russula recondita, ambas muy parecidas en cuanto se refiere al gen ITS, tal y como ya se refleja en el resultado del Blast.
Saludos a tod@s.
Una Russula de las dos que me mandaron los Fungimasters, ante las numerosas dudas que me surgieron a la hora de ponerle apellido, no tuve más remedio que recurrir al análisis molecular, adjunto el resultado del Blast.
Los datos moleculares no parecen dejar lugar a dudas, con una coincidencia del 100%, tanto en lo que se refiere a cobertura como en identidad, apuntado claramente a la:
Russula pectinatoides Peck
Un poco rotas me llegaron las muestras
Esporada en masa de color amarillo IVa-IVb en la escala de Romagnesi.
Reacción débil de las láminas con la Sulfovainillina a tonos entre rosados a violáceos.
Reacción ante el Sulfato ferroso (izquierda) y ante el Guayacol (derecha).
Dermatocistidios dispersos en la suprapellis, con unas medidas de (52.2) 52.23 - 66.7 × (4.8) 4.82 - 6.5 µm., que no se tiñen con la Sulfovainillina.
Los dermatocistidios en agua.
Dermatocistidios en Sulfovainillina.
Cistidios presentes tanto en la arista como en la cara laminar, con unas medidas de (41.9) 48.4 - 63 (63.2) × (7) 7.8 - 11.4 (12.2) µm.
Queilocistidios en Rojo Congo diluido.
Los pleurocistidios.
Basidios con unas medidas de (27.5) 28.5 - 39.6 (41.5) × (7.3) 7.6 - 9 (9.5) µm.
Las esporas obtenidas por esporulación natural y en Reactivo de Melzer.
Estas esporas con unas medidas de:
(5.7) 6.4 - 7.3 (7.8) × (4.9) 5.2 - 5.9 (6.3) µm
Q = (1.1) 1.2 - 1.3 ; N = 30
Me = 6.8 × 5.6 µm ; Qe = 1.2
Observaciones: Aunque ya desde un primer momento tan solo por su borde del sombrero fuertemente acanalado, intuí claramente que se trataba de una Russula dentro de la Sección Pectinatinae, no consideré a la Russula pectinatoides porque se indica un color de esporada de color crema oscuro IIc-IId, muy lejos de la esporada amarilla de mi propuesta (IVa-IVb), tampoco me termina de encajar el comportamiento frente al Sulfato Ferroso, que debería virar a gris rosado y en este caso viró a crema pálido, tampoco el sabor de las láminas que debería de ser acre, y a mí me parecieron dulces.
Parece claro que en el tema de las Russulas, de cuantos más datos dispones, más dudas surgen acerca de su identidad, por lo que en todos los casos termino secuenciando, ya llevo cierto tiempo sin fijarme en ellas, tan solo por lo complicadas que son.
Para terminar añado el árbol filogenético, en esta ocasión he escogido las 20 Russulas más cercanas a mi propuesta, utilizando como Clado externo la Russula amerorecondita.
Mi propuesta se encuentra dentro del clado de la Russula pectinatoides y la Russula recondita, ambas muy parecidas en cuanto se refiere al gen ITS, tal y como ya se refleja en el resultado del Blast.
Saludos a tod@s.
Adjuntos:
Última Edición: 1 año 10 meses antes por Josep Torres. Razón: Una falta de ortografía
El siguiente usuario dijo gracias: Juan Andrés Román
Por favor, Identificarse para unirse a la conversación.
- Javi Calvo
-

- Fuera de línea
- Spammer
-

Menos
Más
- Mensajes: 7009
- Gracias recibidas: 2955
1 año 10 meses antes - 1 año 10 meses antes #109981
por Javi Calvo
Respuesta de Javi Calvo sobre el tema En agradecimiento a los Fungimasters: Russula pectinatoides Peck
Hola Josep, magnífico trabajo el tuyo, ardua tarea la de identificar Russulas, máxime dentro de esta controvertida sección, si se trata en efecto de la verdadera Russula pectinatiodes, que todo indica que si, quedaría descartada totalmente su sinonimia con Russula praetervisa como proponen algunos autores, las diferencias son claras, ya solo a nivel de color de esporada son muy diferentes, quizás el taxón de Sarnari tenga algún error de concepto, creo que el mismo intuye esa posibilidad, ya que en su dia propuso un cambio de nombre para su taxón de confirmarse este término, un tema interesante
Saludos
Saludos
Última Edición: 1 año 10 meses antes por Javi Calvo.
El siguiente usuario dijo gracias: Juan Andrés Román, Josep Torres
Por favor, Identificarse para unirse a la conversación.
- Josep Torres
-
 Autor del tema
Autor del tema
- Fuera de línea
- Moderador
-

Menos
Más
- Mensajes: 8746
- Gracias recibidas: 8379
1 año 10 meses antes #109982
por Josep Torres
Respuesta de Josep Torres sobre el tema En agradecimiento a los Fungimasters: Russula pectinatoides Peck
Gracias Javi.Para intentar de resolver un poco más este tema, he buscado la descripción de la Russula praetervisa en el documento de Sarnari, dejo un pantallazo:
Parece que todos los datos tanto macroscópicos como también a nivel microscópico, entrarían aunque de manera un poco forzada dentro del rango de los del presente estudio, parece ser que a día de hoy ambas especies estarían separadas en base a datos moleculares, ambas con taxón propio, añado una captura de pantalla de Index Fungorum en la que aparece una sinonimia actualmente en desuso.
Como que en el árbol filogenético que he mostrado no aparece la Russula praetervisa, he realizado un nuevo árbol sin utilizar ningún clado externo, en esta ocasión para ello he buscado las 20 Russulas molecularmente más cercanas a mi propuesta, dejo el resultado.
Mi propuesta (la Russula_JTP_2115_24) aparece bien alineada con la Russula pectinatoides, y en el recuadro en un clado distinto la Russula praetervisa.
Queda claro que sin los datos moleculares resulta imposible el que nos podamos inclinar por una u otra opción.
Un abrazo
Parece que todos los datos tanto macroscópicos como también a nivel microscópico, entrarían aunque de manera un poco forzada dentro del rango de los del presente estudio, parece ser que a día de hoy ambas especies estarían separadas en base a datos moleculares, ambas con taxón propio, añado una captura de pantalla de Index Fungorum en la que aparece una sinonimia actualmente en desuso.
Como que en el árbol filogenético que he mostrado no aparece la Russula praetervisa, he realizado un nuevo árbol sin utilizar ningún clado externo, en esta ocasión para ello he buscado las 20 Russulas molecularmente más cercanas a mi propuesta, dejo el resultado.
Mi propuesta (la Russula_JTP_2115_24) aparece bien alineada con la Russula pectinatoides, y en el recuadro en un clado distinto la Russula praetervisa.
Queda claro que sin los datos moleculares resulta imposible el que nos podamos inclinar por una u otra opción.
Un abrazo
Adjuntos:
El siguiente usuario dijo gracias: Juan Andrés Román
Por favor, Identificarse para unirse a la conversación.
- Juan Andrés Román
-

- Fuera de línea
- Spammer
-

Menos
Más
- Mensajes: 2558
- Gracias recibidas: 2756
1 año 10 meses antes #109988
por Juan Andrés Román
Respuesta de Juan Andrés Román sobre el tema En agradecimiento a los Fungimasters: Russula pectinatoides Peck
Gracias por este aporte tan magnífico Josep .............................................. Saludos.
El siguiente usuario dijo gracias: Josep Torres
Por favor, Identificarse para unirse a la conversación.
- Josep Torres
-
 Autor del tema
Autor del tema
- Fuera de línea
- Moderador
-

Menos
Más
- Mensajes: 8746
- Gracias recibidas: 8379
1 año 10 meses antes #109990
por Josep Torres
Respuesta de Josep Torres sobre el tema En agradecimiento a los Fungimasters: Russula pectinatoides Peck
Gracias Juan Andrés.
Para empezar a practicar un poco en este campo tan complejo como es la Biología Molecular, las Russulas han sido mis preferidas.
Ni que decir tiene que los primeros árboles filogenéticos, solo los pude conseguir después de múltiples fracasos, y gracias a la ayuda en privado del gran maestro Tomás Illescas, menuda paciencia ha tenido conmigo.
Un abrazo
Para empezar a practicar un poco en este campo tan complejo como es la Biología Molecular, las Russulas han sido mis preferidas.
Ni que decir tiene que los primeros árboles filogenéticos, solo los pude conseguir después de múltiples fracasos, y gracias a la ayuda en privado del gran maestro Tomás Illescas, menuda paciencia ha tenido conmigo.
Un abrazo
Por favor, Identificarse para unirse a la conversación.
- Foro
- Foros sobre Micología de fungipedia
- Microscopía
- En agradecimiento a los Fungimasters: Russula pectinatoides Peck
Tiempo de carga de la página: 0.271 segundos

Foro de micología